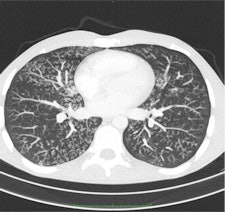

Every radiologist remains keen to reduce radiation dose, but not all of them are tailoring kVp values to suit individual patients, a questionnaire distributed among members of the European Society of Thoracic Imaging has revealed.
General radiologists must use optimal CT protocols to ensure best information at minimal radiation dose, according to Dr. Helmut Prosch.
"The dilemma is: Do we opt for smaller radiation dose or fuller information?" asked Dr. Helmut Prosch, lead author of the survey presented at the European Respiratory Society Annual Congress in Vienna earlier this month. "The survey concluded that most radiologists prefer to obtain volume datasets and reconstruct them in different dimensions for additional information. Such reconstructions of volume datasets can be coronal or sagittal displays, maximal intensity projections, which are not high resolution but provide information on the distribution of nodules, or minimum intensity projections, which show the distribution and extent of emphysema or the details of an enlarged bronchi."
The idea behind the survey, which was conducted between October and December 2011, was to find out exactly what CT protocols are used by experts in chest radiology and what steps they took to reduce radiation dose. The difference in radiation dose can be considerably higher in volume CT scans, but there are a number of possibilities to reduce this dose -- which formed the second focus of the survey.
Around 90% of the 49 respondents used automatic dose modulation, a feature of most modern CT scanners that can modulate the dose per section. As a lung scan covers the shoulder bone, for example, more radiation will be applied, while lower down for other organs, radiation dose will be reduced by up to 30%, explained Prosch, who is section chief of thoracic radiology at the Medical University of Vienna. Other possibilities include adjusting the tube potential (kVp) or current to the tube.
"If you don't want to accept the presets provided by the vendor, you can adjust the dose parameters to the patient's age and weight, in addition to using the dose modulation tool," he said. For example, thin patients could be scanned with 100 kVp compared with 120 kVp in 'normal'-sized patients.

"The message we want to send is that state-of-the art CT protocols should include volume datasets with dose modulation switched on and the tube potential adjusted to the age and size of the patient," Prosch added. "While many radiologists use dose modulation tools, not all define the kVp depending on the patient."
Follow-up exams should optimally be at even lower doses, depending on the disease in question. In diffuse diseases such as lung fibrosis, for example, while a volume CT is preferable as the first diagnostic examination, disease progress can be followed using discontinuous high-resolution CT (HRCT), he noted. However, when looking for or at pulmonary nodules or focal lung diseases, volume CT should be used both initially and in follow-up.
"The members we asked are field experts in chest and thoracic radiology. However, most general radiologists will be performing lung and chest CT, and it is important that these radiologists also learn about our work and use optimal protocols for fullest information at minimal radiation dose," Prosch commented.

The risk of radiation-induced cancer is real but its extent is not yet fully understood, given that current thinking is based mainly on data extrapolated from Hiroshima and that it remains hard to discern radiation-induced cancer from that which is nonradiation induced, he explained. Because CT answers a lot of questions that simple chest x-ray can't, and because treatment depends on these CT results, the modality is being increasingly used, and radiation dose to the whole population is growing year by year.
CT is now used as a diagnostic tool in a number of chest diseases, particularly in lung cancer, pulmonary embolism, interstitial lung diseases, and even to diagnose complications in pneumonia. In the diagnosis of interstitial lung diseases in particular, CT is particularly useful because the pathologic changes in such diseases may be very subtle, necessitating a CT with very thin sections.
A number of potential protocols can be used to evaluate interstitial lung diseases with CT. The two main methods are discontinuous HRCT using 1-mm-thick slices with an intersection gap of 10 to 20 mm and volume CT. Compared with volume CT scans, discontinuous HRCT scans show only 10% of all information.